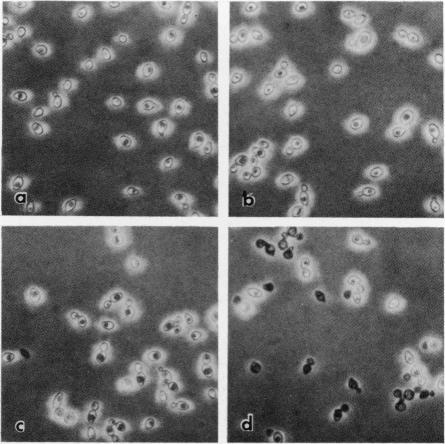
https://cdn.ncbi.nlm.nih.gov/pmc/blobs/5f07/215762/a3b4ee990a5c/jbacter00232-0221-a.jpg

酿酒酵母甘露糖蛋白形成一个决定细胞壁孔隙率的外部细胞壁层。
Saccharomyces cerevisiae mannoproteins form an external cell wall layer that determines wall porosity.
作者信息
Zlotnik H, Fernandez M P, Bowers B, Cabib E
出版信息
J Bacteriol. 1984 Sep;159(3):1018-26. doi: 10.1128/jb.159.3.1018-1026.1984.
A beta-glucanase (Z-glucanase) from Zymolyase was freed from a protease (Z-protease) by affinity chromatography on alpha 2-macroglobulin-Sepharose columns and used to solubilize proteins from isolated cell walls of Saccharomyces cerevisiae. The cell wall proteins were labeled with 125I and subjected to sodium dodecyl sulfate-polyacrylamide gel electrophoresis and autoradiography. The bulk of the labeled material had very low mobility. Its mannoprotein nature was demonstrated by precipitation with specific antibodies and by conversion to a band with an average molecular weight of 94,000 after incubation with endo-beta-N-acetylglucosaminidase. The intact mannoproteins were hydrolyzed by Z-protease, but were resistant to the enzyme when the carbohydrate was first removed by endo-beta-N-acetylglucosaminidase. In intact cells, lysis of cell walls by Z-glucanase required a previous incubation with z-protease, which led to solubilization of most of the 125I-labeled proteins. Other proteases that did not attack the cell wall mannoproteins were unable to substitute for Z-protease. The specific effect of Z-protease is consistent with the notion that mannoproteins form a surface layer of the cell wall that penetrates the wall to some depth and shields glucans from attack by Z-glucanase. Mannoproteins, however, do not appear to cover the inner face of the cell wall, because isolated cell walls, in contrast to intact cells, were completely solubilized by Z-glucanase in the absence of protease. The function of mannoproteins in determining cell wall porosity was highlighted by the finding that horseradish peroxidase (Mr, 40,000) causes lysis of cells that had been treated with Z-protease. Depletion of mannoproteins by Z-protease also resulted in the disappearance of a darkly stained surface layer of the cell wall, as observed by electron microscopy. Other agents that facilitate cell lysis by Z-glucanase, such as 2-mercaptoethanol, digitonin, and high concentrations of salts, caused little or no solubilization of mannoprotein. We assume that they perturb and loosen the structure of the mannoprotein network, thereby increasing its porosity. The implications of our results for the construction of the yeast cell wall and the anchoring of mannoprotein to the cell are discussed.
通过在α2-巨球蛋白-琼脂糖柱上进行亲和层析,从酵母溶壁酶中分离出一种β-葡聚糖酶(Z-葡聚糖酶),使其与一种蛋白酶(Z-蛋白酶)分离,并用该β-葡聚糖酶溶解酿酒酵母分离细胞壁中的蛋白质。细胞壁蛋白用125I标记,然后进行十二烷基硫酸钠-聚丙烯酰胺凝胶电泳和放射自显影。大部分标记物质迁移率很低。通过用特异性抗体沉淀以及在用内切β-N-乙酰氨基葡糖苷酶孵育后转化为平均分子量为94,000的条带,证明了其甘露糖蛋白的性质。完整的甘露糖蛋白可被Z-蛋白酶水解,但在用内切β-N-乙酰氨基葡糖苷酶先去除碳水化合物后,该蛋白对该酶具有抗性。在完整细胞中,Z-葡聚糖酶裂解细胞壁需要事先用Z-蛋白酶孵育,这导致大部分125I标记的蛋白质溶解。其他不攻击细胞壁甘露糖蛋白的蛋白酶无法替代Z-蛋白酶。Z-蛋白酶的特异性作用与以下观点一致,即甘露糖蛋白形成细胞壁的表面层,该表面层穿透细胞壁一定深度并保护葡聚糖不被Z-葡聚糖酶攻击。然而,甘露糖蛋白似乎并未覆盖细胞壁的内表面,因为与完整细胞相比,分离的细胞壁在没有蛋白酶的情况下可被Z-葡聚糖酶完全溶解。辣根过氧化物酶(分子量40,000)可导致经Z-蛋白酶处理的细胞裂解,这一发现突出了甘露糖蛋白在决定细胞壁孔隙率方面的作用。通过电子显微镜观察,Z-蛋白酶使甘露糖蛋白减少也导致细胞壁深色染色表面层消失。其他促进Z-葡聚糖酶裂解细胞的试剂,如2-巯基乙醇、洋地黄皂苷和高浓度盐,对甘露糖蛋白的溶解作用很小或没有作用。我们认为它们扰乱并疏松了甘露糖蛋白网络的结构,从而增加了其孔隙率。讨论了我们的结果对酵母细胞壁构建以及甘露糖蛋白与细胞锚定的意义。